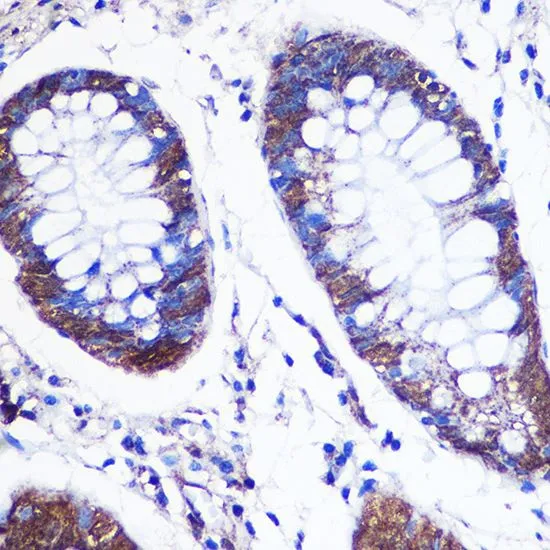

IP analysis of Jurkat cell lysate using GTX65884 LSM4 antibody. Antibody amount : 1microg / 200microg lysate Dilution : 1:1000
LSM4 antibody
GTX65884
ApplicationsImmunoFluorescence, ImmunoPrecipitation, Western Blot, ImmunoCytoChemistry, ImmunoHistoChemistry, ImmunoHistoChemistry Paraffin
Product group Antibodies
ReactivityHuman
TargetLSM4
Product GTX65884 is not available
Product not available
There may be an alternative product available, please contact our technical support team.
Overview
- SupplierGeneTex
- Product NameLSM4 antibody
- Delivery Days Customer9
- ApplicationsImmunoFluorescence, ImmunoPrecipitation, Western Blot, ImmunoCytoChemistry, ImmunoHistoChemistry, ImmunoHistoChemistry Paraffin
- CertificationResearch Use Only
- ClonalityPolyclonal
- ConjugateUnconjugated
- Gene ID25804
- Target nameLSM4
- Target descriptionLSM4 homolog, U6 small nuclear RNA and mRNA degradation associated
- Target synonymsglycine-rich protein; GRP; LSM4 homolog, U6 small nuclear RNA associated; LSM4 U6 small nuclear RNA and mRNA degradation associated; U6 snRNA-associated Sm-like protein LSm4; YER112W
- HostRabbit
- IsotypeIgG
- Scientific DescriptionThis gene encodes a member of the LSm family of RNA-binding proteins. LSm proteins form stable heteromers that bind specifically to the 3-terminal oligo(U) tract of U6 snRNA and may play a role in pre-mRNA splicing by mediating U4/U6 snRNP formation. Alternatively spliced transcript variants encoding multiple isoforms have been observed for this gene. [provided by RefSeq, Nov 2011]
- ReactivityHuman
- Storage Instruction2°C to 8°C,-20°C or -80°C
- UNSPSC12352203